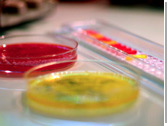

CALIDAD
En Interalimen somos conscientes de que una distribución eficaz solo satisface parcialmente las necesidades de nuestros clientes. Nuestro objetivo es apoyar al cliente en todas las áreas esenciales en el proceso productivo para que, al igual que nosotros, se destaquen de sus competidores.
En Interalimen somos conscientes de que una distribución eficaz solo satisface parcialmente las necesidades de nuestros clientes. Nuestro objetivo es apoyar al cliente en todas las áreas esenciales en el proceso productivo para que, al igual que nosotros, se destaquen de sus competidores.


Nuestro Departamento Técnico también ofrece asesoría técnica en productos y procesos industriales, diseño, control y análisis del producto final. Nuestros laboratorios nos permiten un estudio químico, físico y microbiológico de todos nuestros productos, y están provistos de instrumental científico para la realización de controles analíticos de
calidad, de acuerdo con las exigencias legislativas y requerimientos tecnológicos.
Para nosotros el proceso documental (ISO 9001-2000) se ha convertido en una parte esencial del control de calidad. Orientado al cliente y en proceso de mejora continua, nos permite entregar producto siempre dentro de las especificaciones contratadas